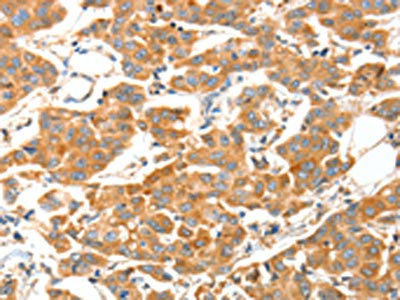

ADAMTS18 Antibody
-
中文名稱:ADAMTS18兔多克隆抗體
-
貨號:CSB-PA903364
-
規格:¥1100
-
圖片:
-
The image on the left is immunohistochemistry of paraffin-embedded Human breast cancer tissue using CSB-PA903364(ADAMTS18 Antibody) at dilution 1/30, on the right is treated with fusion protein. (Original magnification: ×200)
-
The image on the left is immunohistochemistry of paraffin-embedded Human cervical cancer tissue using CSB-PA903364(ADAMTS18 Antibody) at dilution 1/30, on the right is treated with fusion protein. (Original magnification: ×200)
-
-
其他:
產品詳情
-
Uniprot No.:
-
基因名:
-
別名:ADAMTS18 antibody; ADAMTS21A disintegrin and metalloproteinase with thrombospondin motifs 18 antibody; ADAM-TS 18 antibody; ADAM-TS18 antibody; ADAMTS-18 antibody; EC 3.4.24.- antibody
-
宿主:Rabbit
-
反應種屬:Human,Mouse
-
免疫原:Fusion protein of Human ADAMTS18
-
免疫原種屬:Homo sapiens (Human)
-
標記方式:Non-conjugated
-
抗體亞型:IgG
-
純化方式:Antigen affinity purification
-
濃度:It differs from different batches. Please contact us to confirm it.
-
保存緩沖液:-20°C, pH7.4 PBS, 0.05% NaN3, 40% Glycerol
-
產品提供形式:Liquid
-
應用范圍:ELISA,IHC
-
推薦稀釋比:
Application Recommended Dilution ELISA 1:2000-1:5000 IHC 1:50-1:200 -
Protocols:
-
儲存條件:Upon receipt, store at -20°C or -80°C. Avoid repeated freeze.
-
貨期:Basically, we can dispatch the products out in 1-3 working days after receiving your orders. Delivery time maybe differs from different purchasing way or location, please kindly consult your local distributors for specific delivery time.
-
用途:For Research Use Only. Not for use in diagnostic or therapeutic procedures.
相關產品
靶點詳情
-
基因功能參考文獻:
- In summary, we demonstrate that ADAMTS18 silencing in breast cancer is significantly correlated with promoter CpG methylation. ADAMTS18 acts as an antagonist of AKT and NF-kappaB signaling, further suppressing EMT and metastasis of breast cancer cells. PMID: 28503860
- This study showed that ADAMTS1, 8, and 18 are highly expressed in GC and its nodal metastases, suggesting important roles of these proteases in carcinogenesis and lymphatic metastasis. The findings from the present study indicate that these proteases may be promising candidates for novel and alternative treatments in GC (gastric cancer) PMID: 28814085
- Studies suggest that ADAM metallopeptidase with thrombospondin type 1 motif, 18 protein (ADAMTS-18) as a promising diagnostic and therapeutic target. PMID: 24896365
- Novel homozygous mutations in ADAMTS18 were identified, consisting of c.1067T>A [p.L356*] in the first proband, c.2159G>C [p.C720S] in the 2 affected brothers PMID: 24874986
- Results suggest that ADAMTS18 plays an essential role in early eye development and that mutations therein cause a distinct eye phenotype that is mainly characterized by microcornea and myopia. PMID: 23818446
- study reveals that mutations in the ADAMTS18 gene can cause a broad phenotypic spectrum of eye disorders and contribute to shed further light on the complexity of retinal diseases PMID: 23356391
- the study identified ADAMTS18 as the only gene carrying a homozygous protein altering mutation. PMID: 21862674
- ADAMTS18 mutations promote growth, migration, and metastasis in melanoma PMID: 21047771
- ADAMTS18 gene methylation in 3 types of cancers was significantly higher than normal tissues. No significant association was found between methylation status & TNM staging. Epigenetic regulation of ADAMTS18 was associated with carcinogenesis. PMID: 19806480
- Functional epigenetics show ADAMTS18 to be a novel functional tumor suppressor, being frequently inactivated epigenetically in multiple carcinomas. PMID: 17546048
- ADAMTS18 and TGFBR3 might underlie BMD determination in the major human ethnic groups. PMID: 19249006
顯示更多
收起更多
-
相關疾病:Microcornea, myopic chorioretinal atrophy, and telecanthus (MMCAT)
-
亞細胞定位:Secreted, extracellular space, extracellular matrix.
-
組織特異性:Expressed in fetal lung, liver, and kidney and in adult brain, prostate, submaxillary gland, and endothelium.
-
數據庫鏈接:
Most popular with customers
-
-
YWHAB Recombinant Monoclonal Antibody
Applications: ELISA, WB, IHC, IF, FC
Species Reactivity: Human, Mouse, Rat
-
-
-
-
-
-